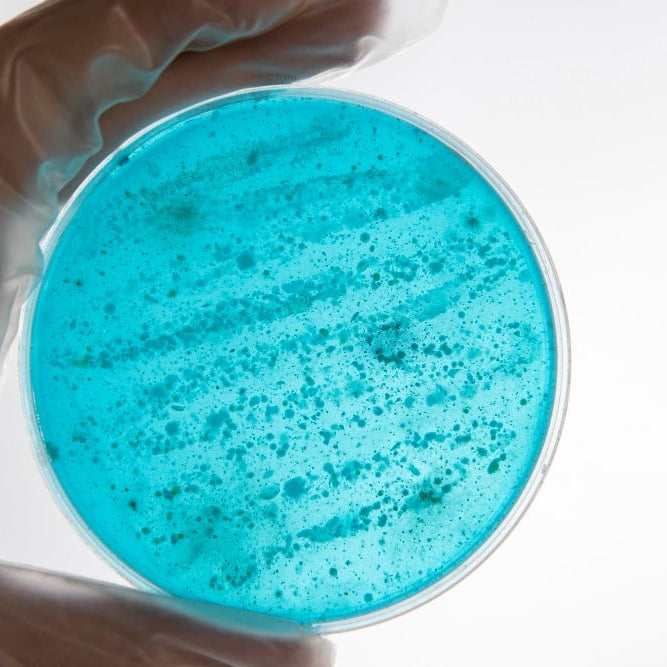
¿Cómo se Contagia la Legionella? - Remi Hogar

Tratamiento para Legionella
El tratamiento de Legionella combina cloro, termalización a 60°C y tecnologías avanzadas como radiación UV e ionización para una eliminación efectiva.
Leer ahora

€100,00 de envío gratuito!
